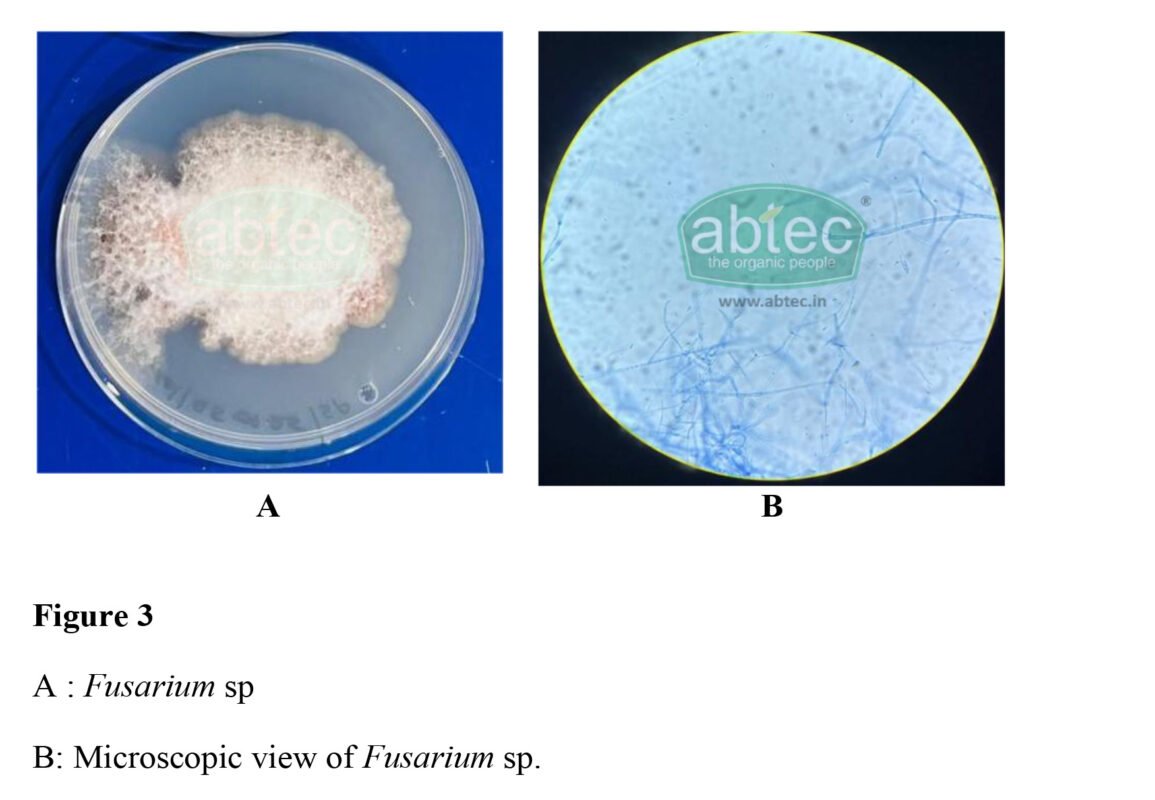
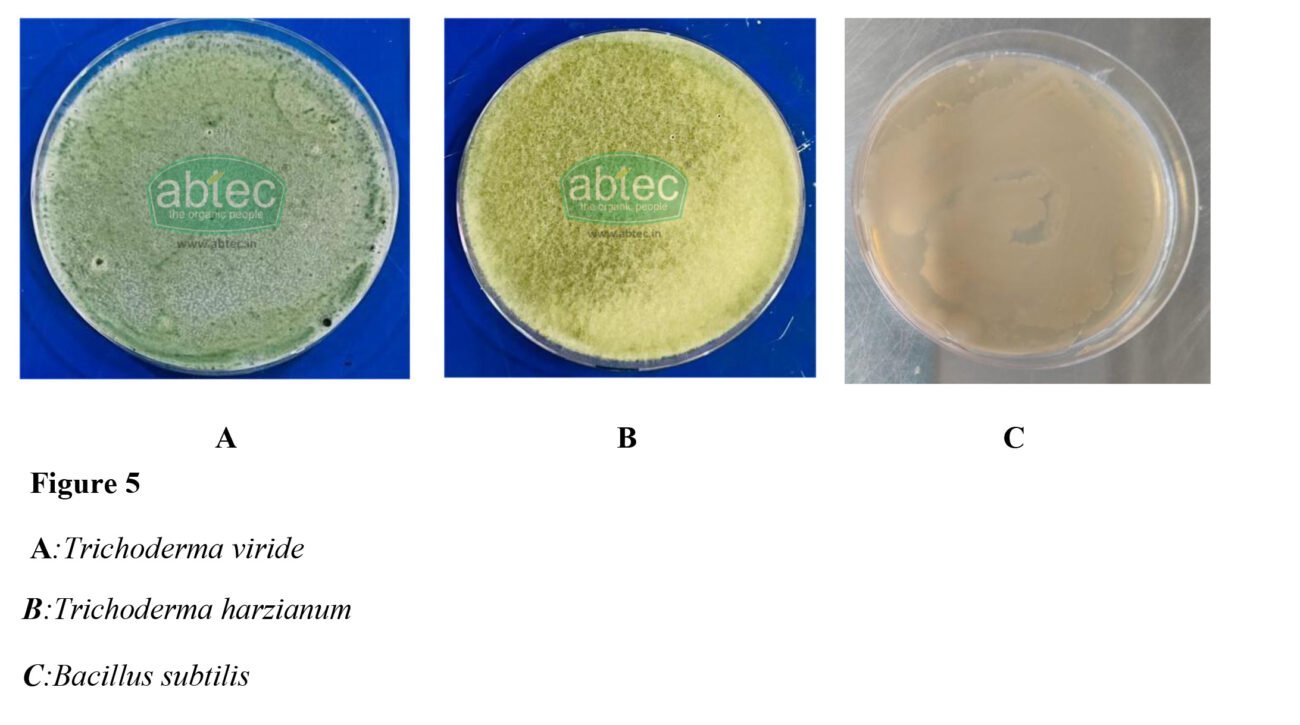
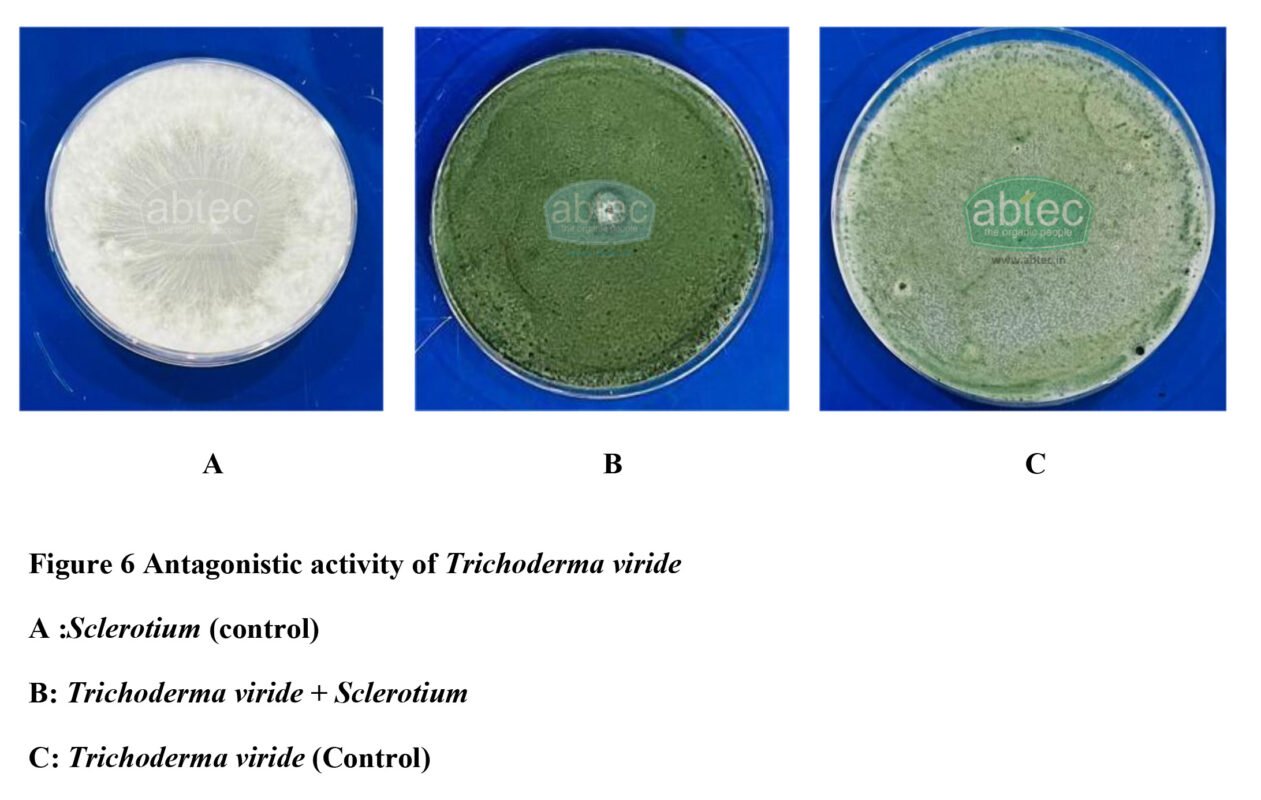
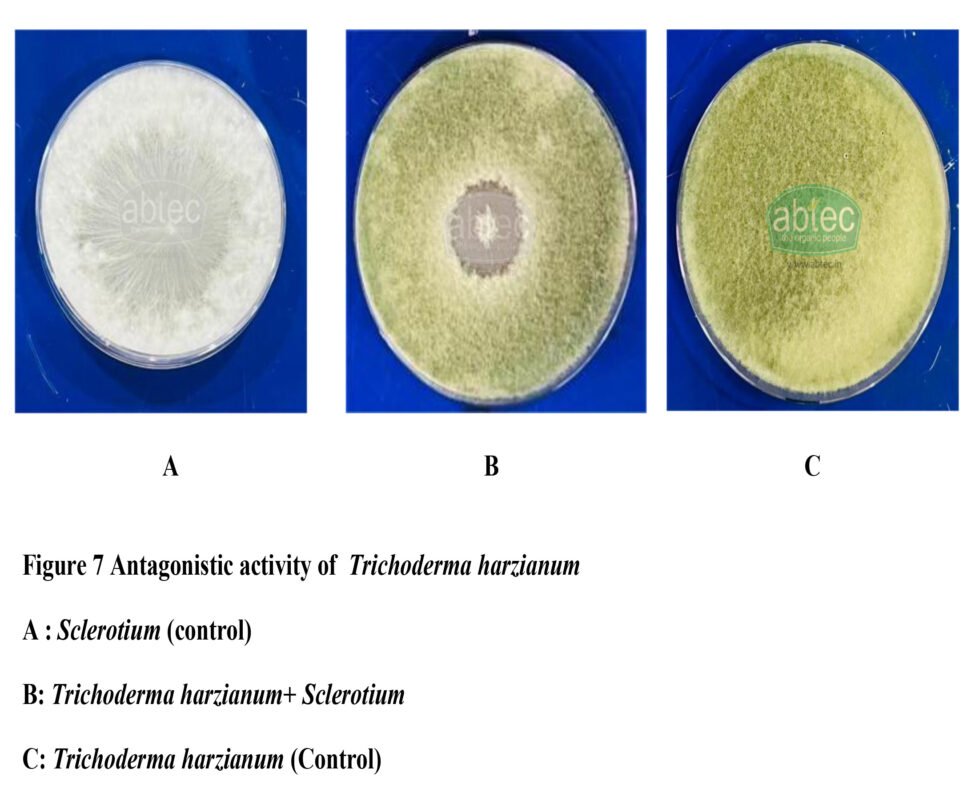
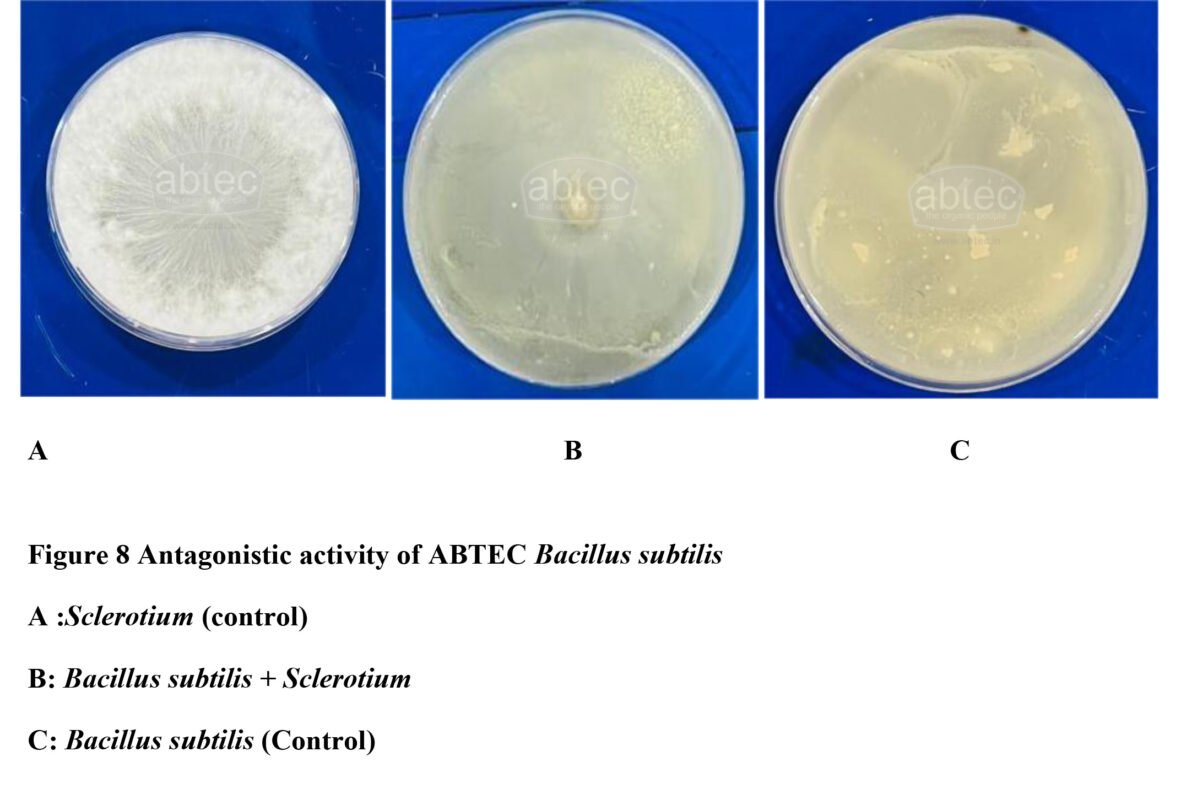

Harnessing Plant Growth Promoting Microorganisms as Biocontrol agents: An Eco-friendly Alternative to the use of Agrochemicals in Plant Disease Management.
Plant pathogens vary greatly in complexity, beginning from small viroids to higher plants, causing diseases in crop sand resulting in the retardation of plant growth development and decrease in yield and quality. Severe infections may lead to complete plant death (Strange et al ., 2005). Plant diseases can be classified according to the type of pathogens involved, as fungal diseases, bacterial diseases, viral diseases and nematode diseases (Agrios,2005).
The appearance of plant diseases can be affected by various factors, including species and host plants, the pathogenecity and virulence of pathogens, environmental conditions such as temperature, humidity, light and soil type, as well as human factors such as cultivation management measures (Burdon etal., 2006). Pathogens may be dispersed through air, water, soil, infected or contaminated plant materials, seeds, insects and other animals (Fitt et al., 2006). Crops have become more vulnerable to diseases and the emergence of new pathogen scan be driven by multiple factors like genetic changes, environmental changes, agricultural practices, global trade and movement and changes in host susceptibility. Once a pathogen infects a crop, it can quickly destroy the entire field (Sourav et al., 2024).
Plant diseases considerably reduce crop yield and productivity there by negatively affecting the global economy (Anand & Rajeshkumar, 2022). Indian agriculture is considered as a global power house. The primary concerns faced by Indian agriculture include outbreaks of pests and disease, poor soil fertility, unavailability of sufficient water and climate change ( Smriti et al., 2022). Plant pathogens can have severe impact on plant healthand can also affect humans and animals by the secretion of toxic metabolites called mycotoxins (Al-sadi & A. M, 2017).
Among these plant pathogens, fungal pathogens are one of the key-concerns and they are a major yield limiting factor that leads to economic loss, market declines and unemployment in agriculture and food sector.
The fungal pathogen Phythophthora is one of the reason for diseases in numerous nursery fruit and vegetable crops (Hong et al., 2005).Phytophthora species have the ability to infect trees and shrubs as foliar, bark or root pathogens (Obwald et al., 2014). Phytophthora infestans, the cause of potato blight, triggered the Irish Potato famine in 1840s.
Pathogens belonging to the Fusarium genus are the reason for most of the significant crop diseases worldwide. Fusarium species are soil borne vascular wilt pathogens which are the most phytopathogenic and toxigenic fungi (Okungbowa & Shittu, 2012). In India Fusarium is a major pathogen that cause wilt in sugar cane stalks and it severely affects cane production and productivity, which is one of the major food and bio energy crop.
Sclerotium is another fungal pathogen that affects economically valuable crops. The genus of Sclerotium causes collar rot, Sclerotium wilt, stem rot, charcoal rot, seedling blight, damping-off, foot- rot, stem blight and root- rot (Dwivedi & Prasad, 2016).
These fungal diseases significantly affect crop yield and productivity. This causes a decline in the global economy at large and there is a need to develop an innovative management strategy. Biocontrol is a captivating and sustainable alternative compared to chemical pesticides.
Microorganismscontrol the fungal pathogens by hyper parasitism, predation, antibiosis, cross protection, competition for site and nutrient and induced resistance (Heydari et al., 2010).
Trichoderma viride, Trichoderma harzianum, and Bacillus subtilis are effective Biocontrol agents for the management of diseases in plants.
Trichoderma harzianum significantly controlled the disease caused by Sclerotium in beans, cotton and tomato, resulting in an increased yield (Elad et al., 1979). The combined use of Pseudomonas with Bacillus subtilis can lead to greater plant protection from Sclerotium (Abeysinghe, 2009). Trichoderma viride showed antifungal activity towards Sclerotium(Doley et al., 2012).
In a study conducted in tomato plant, which was affected with Fusarium wilt,Trichoderma isolate effectively controlled the disease and significantly increased the plant height (Sundaramoorthy & Balabaskar, 2013). Similarly Bacillus species also showed significant reduction in Fusarium wilt diseasesin Tomato (Jangir et al., 2018). Trichoderma harzianum controlled Fusarium wilt in cotton and muskmelon in both soil and seed treatment (Sivan & Chet, 1986).
Trichoderma viride can significantly reduced the disease, potato blight caused by Phytophthora infestants (Zegeyeet al., 2011).Bacillus sp when tested against Phytophthora species isolated from infected crop of potato, showed significant growth inhibition (Caulier et al., 2018). In a study conducted in Phytophthora infected leafs of potato and tomato, it was found that Trichoderma harzianum is a highly significant antagonistic agent that inhibited the mycelial growth of pathogen (Fatima et al., 2015).
So the present study aimed at identifying the pathogen and controlling the disease by providing ABTEC Biocontrol agents and thus aimed at ensuring zero chemical pesticide residues in agricultural produce to achieve quality as well as safety.
The infected plant samples were collected from Orchiroids indoor plants, Pothencode , Trivandrum Kerala .The infectedplant parts were surface sterilized and cultured on Potato Dextrose Agar medium and incubated for pathogen isolation. The fungal growth was sub cultured and the pathogen was identified based on morphological characterists and microscopic observation.

Isolation and identification of the pathogen
The infected plant parts were surface sterilized and cultured on Potato Dextrose Agar medium and incubated for pathogen isolation. Three fungal pathogens were isolated and eachisolates showed variation in colony morphology such as colour of the colony, growth rate, shape of the margin, texture of the colony etc. Microscopic observation showed distinct spore and hyphal structures for each isolates.
The first isolate exhibited typical colony morphology of Sclerotium. On PDA the colony showed fast growth with white cottony mycelium (Figure 2 A). The microscopic observation revealed the presence of septate hyphae with clamp connections (Figure 2 B). These features confirmed that the isolate belongs to the genus Sclerotium sp.

B: Microscopic view of Sclerotium sp.
The second isolate exhibited a cottony mycelium which initially appears pale pink in colour and later become purple (Figure 3 A). The microscopic observation showed septate hyphae with microconidia (Figure 3 B). These features confirmed that this isolate belonged to Fusarium sp.
The third isolate exhibited a fluffy mycelium; initially appearing off-white and later changing to faintly yellowish (Figure 3 A). The microscopic observation revealed the presence of septate hyphae with lemon shaped sporangia and Oospores (Figure 3 B).This characteristic features confirm that the isolate belong to Phytophthora sp.

Biocontrol agents appear to be most promising tool to control these pathogens and thus ensuring plant health. Therefore ABTEC Biocontrol agents such as Trichoderma viride (Figure 5 A),Trichoderma harzianum (Figure 5 B), Bacillus subtilis (Figure 5C), and Pseudomonas fluorescens (Figure 5 D) was evaluated for its antagonistic activity against the isolated pathogens.
ABTEC Biocontrol agents were tests against the isolated pathogens. The ABTEC Biocontrol agents showed different levels of antagonistic activity against the isolated pathogens
The Antagonistic activity of ABTEC Biocontrol agents against Sclerotium.
- Antagonistic activity of ABTEC Trichoderma viride against Sclerotium
ABTEC Trichoderma viride showed the strongest antagonistic effect against the isolated pathogen, Sclerotium. ABTEC Trichoderma viride clearly overgrowing and suppressing the pathogen, through mechanisms such as competition for space and nutrients, parasitization and disintegration of the pathogen hyphae by enzymes and antagonism (Figure 6 )
2. Antagonistic activity of ABTEC Trichoderma harzianum against Sclerotium
ABTEC Trichoderma harzianum also showed substantial inhibition against Sclerotium. T.harzianum grew better than Sclerotium and invaded its mycelium under growth condition and there was a clear zone of inhibition between Sclerotium and T. harzianum (Figure 7).
3. Antagonistic activity of ABTEC Bacillus subtilis against Sclerotium
ABTEC Bacillus subtilis also showed significant antagonistic activity against Sclerotium by a marked reduction in mycelial growth of the pathogen, a distinct zone of inhibition between B.subtilis and Sclerotium
4. Antagonistic activity of ABTECTrichoderma viride againstFusarium.
ABTEC Trichoderma viride exhibited strong antagonistic activity against Fusarium sp.ABTEC Trichoderma viride rapidly colonized and overgrew the pathogen, completely restricting the radial growth of Fusarium, likely through mycoparasitism. No distinct inhibition zone was observed, indicating suppression through overgrowth and competitive exclusion (Figure 9 )

5.Antagonistic activity of ABTEC Trichoderma harzianumagainst Fusarium.
ABTEC Trichoderma harzianum also exhibited a strong antagonistic activity against Fusarium. T. harzianum significantly restricted the radial growth of the Fusarium. The dominance of T.harzianum growth suggests suppression is mainly through competitive exclusion and mycoparasitism (Figure 10).

6.Antagonistic activity of ABTEC Bacillus subtilis against Fusarium
ABTEC Bacillus subtilis stronglyinhibited the growth of Fusarium sp., There is a distinct zone of inhibition around the Fusarium inoculation point. The pathogen Fusarium remains confined to the centre, showing that the radial growth of the Fusarium is restricted. This indicates that the Biocontrol agent Bacillus subtilis suppress the pathogen through antibiosis rather than direct overgrowth.

Antagonistic activity of ABTEC Trichoderma viride against Phytophthora
ABTEC Trichoderma viride exhibited strong antagonistic activity against Phytophthora. T. viride rapidly colonized and overgrew the pathogen. No distinct inhibition zone was observed, indicating suppressionis primarily through competitive exclusion and mycoparasitic interaction, rather than antibiosis alone. (Figure 12)

Antagonistic activity of ABTEC Trichoderma harzianum against Phytophthora
ABTECTrichoderma harzianumalsoexhibited strong antagonistic activity against Phytophthora. T. harzianum rapidly colonized and completely suppressed the growth of Phytophthora. The suppression is mainly through rapid overgrowth and direct hyphal interaction (Figure 13).

Antagonistic activity of ABTEC Bacillus subtilis against Phytophthora
ABTEC Bacillus subtilis exhibited significant antagonistic activity against Phytophthora. The radial growth of the pathogen was markedly restricted.

This study confirms that ABTEC Trichoderma viride, Trichoderma harzianum and Bacillus subtilis are potential Biocontrol agents for the effective management of various diseases affecting plants.
Recommended Products
-
ABTEC Herbal Mosquito Repellent 50ml
₹99.00Original price was: ₹99.00.₹95.00Current price is: ₹95.00. -
ABTEC Herbal Mosquito Repellent 100ml
₹240.00Original price was: ₹240.00.₹235.00Current price is: ₹235.00.